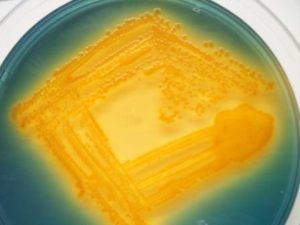
yellow colored colonies of Vibrio cholorae in TCBS culture medium - Yellow-colored colonies ofVibrio choleraein TCBS culture medium

Thiosulfate citrate bile salts sucrose (TCBS) agar is a selective as well as differential culture medium used for selective isolation of  Vibriospp from a variety of clinical and nonclinical specimens. Vibrio choleraeis the causative agent of cholera. Other Vibriospecies have been associated with gastroenteritis and extraintestinal infections, especially of the ear, soft tissue, and blood.
TCBS has a very high pH (8.5-9.0) which suppresses the growth of intestinal flora other than Vibriospp. The bile salts inhibit the growth of gram-positive microorganisms.
Vibriospp produce either yellow or green colonies on TCBS, depending on whether they are able to ferment sucrose. If the sucrose is fermented, yellow colonies are produced. Vibrio cholerae produces yellow colonies in TCBS whereas Vibrio parahaemolyticus produces green colonies.
Composition
- Yeast extract, bacteriological peptone: provides the nitrogen, vitamins, and amino acids in TCBS agar
- Sodium thiosulphate, Sodium citrate: Â selective agents providing an alkaline pH to inhibit Gram-positive organisms and suppress coliforms
- Ox Bile: Bile salts inhibit growth of gram-positive microorganisms
- Sucrose: fermentable carbohydrate
- Sodium chloride: provide optimum growth and metabolic activity of halophilic Vibrio spp.
- Ferric citrate: Sodium thiosulfate is also a sulfur source, and acts with ferric citrate as an indicator to detect hydrogen sulfide production.
- Bromothymol blue/ thymol blue: pH indicator.
- Agar: Solidifying agent.
pH 8.6 ± 0.2 @ 25°C **(note the alkaline pH):**An increased pH is used to enhance growth of Vibrio cholerae, because this organism is sensitive to acid environments.
Preparation of TCBS Agar
TCBS agar is commercially available or can be prepared from ready to use dehydrated powder purchased from suppliers of culture media. Prepare as described by the manufacturer.
- Suspend 88 g of the medium in one liter of purified water (concentration may vary depending on the manufacturer).
- Heat with frequent agitation and boil for one minute to completely dissolve the medium. Do not over-heat the medium.
- DO NOT AUTOCLAVE.
- Dispense aseptically in sterile Petri dishes. Date the medium and give it a batch number.
- Store the plates at 2-8°C, in sealed plastic bags to prevent loss of moisture.
Shelf-life: TCBS agar is green when prepared. Up to 4 weeks or longer providing there is no change in the appearance of the medium to suggest contamination or alteration of pH. pH of the medium: This should be within the range of pH 8.4- 8.8 at room temperature.
Quality control
A medium of good quality gives the following mentioned results when cultured at 35°C in aerobic condition for 18-24 hours
- Vibrio parahaemolyticus ATCC® 17802: Growth; blue-green centered colonies
- Escherichia coli ATCC® 25922: Partial to complete inhibition; small, clear colonies
Colony characteristics
Results of culture are read after overnight culture (18 to 24 hours).
- V. cholerae will produce large (2 to 4 mm in diameter), slightly flattened, yellow colonies with opaque centers and translucent peripheries. V. cholerae and its biotype Eltor ferment sucrose, this results in a decrease in pH and production of yellow colonies.
- V. parahaemolyticus, produce green to blue-green colonies as it does not ferment sucrose.
Suspicious colonies for further testing should be subcultured to a noninhibitory medium, such as triple sugar iron agar (TSI).
Limitation of TCBS Agar
- TCBS Agar may not support the good growth of some Vibrio spp. (e.g., V. hollisae and V. metschnikovii). The identification of the various Vibriospp. on TCBS Agar is presumptive and further tests are required for confirmation.
- It is recommended that non-selective media be used in conjunction with selective media for optimum recovery of pathogenic organisms.
- Cultures grown on TCBS should be examined immediately after removal from the incubator as yellow colonies of Vibrio spp. (e.g., V. cholerae) may revert to a green color when left at room temperature.
References
- Pfeffer, C., & Oliver, J. D. (2003). A comparison of thiosulphate-citrate-bile salts-sucrose (TCBS) agar and thiosulphate-chloride-iodide (TCI) agar for the isolation of Vibrio species from estuarine environments. Letters in applied microbiology, 36(3), 150–151. https://doi.org/10.1046/j.1472-765x.2003.01280.x
- Lotz, M. J., Tamplin, M. L., & Rodrick, G. E. (1983). Thiosulfate-citrate-bile salts-sucrose agar and its selectivity for clinical and marine vibrio organisms.  Annals of clinical and laboratory science, 13(1), 45–48.
- Chen, M., Li, H., Ma, Y., Shi, Y., Fu, Y., Zheng, T., Zheng, S., & Chen, B. (2012). Wei sheng wu xue bao = Acta microbiologica Sinica, 52(5), 637–644.
- Forbes, S., Sahm, D. F., & Weissfeld, A. S. (2002). Bailey & Scott’s Diagnostic Microbiology. Mosby.